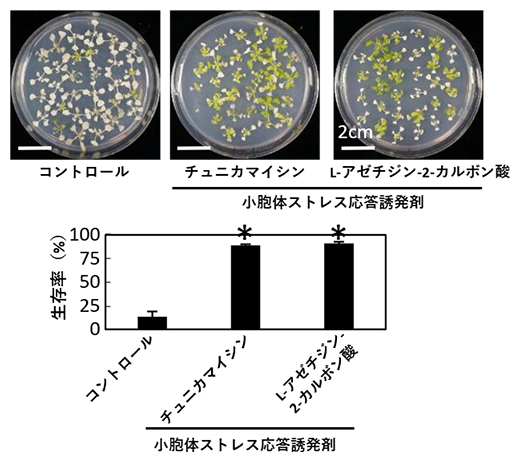
小胞体ストレス応答誘発剤による高温ストレス耐性強化の図

理化学研究所(理研)環境資源科学研究センター植物ゲノム発現研究チームの関原明チームリーダー、松井章浩研究員(研究当時)、戸高大輔研究員らの共同研究グループは、植物へのエタノールの投与により、高温ストレス耐性が強化されることを発見しました。
本研究成果は、農作物の高温耐性を強化する肥料や技術の開発に貢献すると期待できます。
小胞体[1]の中では、生命現象の維持に必須なタンパク質の折り畳みなどが行われています。さまざまな環境ストレスにより、折り畳みが不完全なタンパク質が小胞体内に過剰に蓄積してしまった状態を「小胞体ストレス」と呼びます。
今回、共同研究グループは、モデル植物のシロイヌナズナに安価で入手しやすいエタノールを投与し、遺伝子発現や代謝産物の量的変化を網羅的に解析したところ、「小胞体ストレス応答(UPR)[1]」が高温ストレス耐性の獲得に関与していることが示唆されました。そこで、小胞体ストレス応答に関わる薬剤処理実験や変異体の解析を行った結果、エタノール投与により小胞体ストレス応答が促進されることで、高温ストレス耐性が強化されることが明らかになりました。また、エタノール投与によってレタスの高温ストレス耐性も強化できることが分かりました。
本研究は、科学雑誌『Plant Molecular Biology』オンライン版(6月22日付:日本時間6月22日)に掲載されました。

シロイヌナズナにおけるエタノール投与による高温ストレス耐性の強化
背景
地球温暖化などの気候変動により、熱波などの異常気象の発生が増加しています。厳しい高温条件は植物にとってストレス要因であり、作物にダメージを与え収量が低下します。また、2050年までに世界の人口は100億人に達すると予想され、食糧不足が懸念されています。これらの課題を解決する有効な手段の一つとして、高温などの環境ストレスに強い植物(環境ストレス耐性植物)を創出する技術を開発し、作物に応用することが挙げられます。
関原明チームリーダーらはこれまでに、安価で入手しやすいエタノールの投与によって、植物の塩ストレス耐性や強光ストレス耐性が強化されることを報告しました注1、2)。本研究では、エタノール投与による高温ストレス耐性の変化を調べました。
- 注1)2017年7月3日JSTプレスリリース「エタノールが植物の耐塩性を高めることを発見」
- 注2)Sako, K., Nagashima, R., Tamoi, M. and Seki, M. (2021) Exogenous ethanol treatment alleviates oxidative damage of Arabidopsis thaliana under conditions of high light stress. Plant Biotechnol. 38: 339-344.
研究手法と成果
共同研究グループは、ポットに植えられたモデル植物のシロイヌナズナを20ミリモーラー(mM)(0.117%)のエタノール水溶液が入ったトレーに3日間置くことでエタノール投与をしたところ、50℃の環境下に3時間置いた場合の生存率が上昇する、すなわち高温ストレス耐性が向上することを発見しました(図1A)。また、エタノールによる高温ストレス耐性の強化はレタスでも有効であることを示しました(図1B)。

図1 エタノールによる高温ストレス耐性強化
- (a)シロイヌナズナへのエタノール事前投与により、高温ストレスにさらされても生き延びる個体が増えた。
- (b)レタスへのエタノール事前投与により、高温ストレス下での生育が良好になった。写真は圃場での栽培試験の結果。高温条件を実現するため意図的にビニールトンネル内で栽培した。トンネル内の温度は最大35~40℃に達した。
次に、エタノールによる高温ストレス耐性強化のメカニズムを明らかにするため、遺伝子発現や代謝産物の量的変化をトランスクリプトーム解析[2]やメタボローム解析[3]により網羅的に調べた結果、「小胞体ストレス応答(UPR)」の関与が示唆されました。細胞小器官の一つである小胞体の中では、生命現象の維持に必須なタンパク質の加工(折り畳み)などが行われます。「小胞体ストレス」とは、折り畳みが不完全なタンパク質が小胞体内に過剰に蓄積した状態のことで、これを回避するシステムを小胞体ストレス応答といいます。
小胞体ストレス応答がエタノールによる高温耐性強化とどのように関わっているのかを明らかにするため、小胞体ストレス応答を促進・阻害する薬剤処理実験(図2)や小胞体ストレス応答に関連する変異体の解析を行いました。その結果、エタノール投与によって小胞体ストレス応答が促進され、高温ストレス耐性が強化されることが明らかになりました(図3)。
図2 小胞体ストレス応答誘発剤による高温ストレス耐性強化
小胞体ストレス応答を促進させる誘発剤(チュニカマイシンおよびL-アゼチジン-2-カルボン酸)をシロイヌナズナに事前に投与すると、高温ストレスにさらされても生き延びる個体が増えた。43.5℃の環境下に3時間置いて高温ストレスを与えた。

図3 エタノール投与によるの高温ストレス耐性強化のメカニズム
- (左)エタノールを投与していない植物が高温にさらされると、小胞体ストレス応答(UPR)によるタンパク質の正常なフォールディング(折り畳み)が行われず、ストレス耐性は低い。
- (右)エタノールを投与すると、UPRの制御因子の一つであるbZIP60とその標的のBIP3が活性化され、正常なタンパク質の折り畳み機構が向上することで、ストレス耐性が強化される。
今後の期待
本研究では、安価で入手しやすいエタノールをモデル植物であるシロイヌナズナに投与すると、高温ストレス耐性が向上することを発見しました。この技術は、圃場で栽培されたレタスでも同様の効果を示しました。従って本技術は、レタスなどの葉物野菜をはじめとする作物の生産現場へ応用できると期待できます。
今回の研究は、国際連合が2016年に定めた17項目の「持続可能な開発目標(SDGs)[4]」のうち「2.飢餓をゼロに」や「13.気候変動に具体的な対策を」などへの貢献が期待できます。
補足説明
- 1.小胞体、小胞体ストレス応答(UPR)
小胞体は、真核生物の細胞内に存在する膜状構造の細胞小器官の一種。この器官内では、生命現象の維持に必須なタンパク質の加工(折り畳み)や糖鎖などの修飾が行われる。小胞体ストレスとは、折り畳みが不完全なタンパク質が小胞体内に過剰に蓄積してしまった状態を意味する。タンパク質の加工プロセスは外部環境の変化に非常に敏感であり、高温や乾燥、病害などのさまざまな刺激を受けると、正しく加工されていない不完全なタンパク質が蓄積してしまう。真核生物はこのような状態を回避するシステムを持っており、そのシステムを小胞体ストレス応答と呼ぶ。UPRはUnfolded protein responseの略。 - 2.トランスクリプトーム解析
細胞中に存在する全てのRNAの発現プロファイルを網羅的に解析すること。遺伝子の機能解析や遺伝子ネットワークの解析などに利用されている。 - 3.メタボローム解析
メタボロームは細胞内で合成された低分子代謝産物の総体を指す。植物における総代謝物質は20万~100万種と考えられている。メタボローム解析とは、このメタボロームを網羅的に測定・解析すること。 - 4.持続可能な開発目標(SDGs)
2015年9月の国連サミットで採択された「持続可能な開発のための2030アジェンダ」にて記載された2016年から2030年までの国際目標。持続可能な世界を実現するための17のゴール、169のターゲットから構成され、発展途上国のみならず、先進国自身が取り組むユニバーサル(普遍的)なものであり、日本としても積極的に取り組んでいる(外務省ホームページから一部改変して転載)。
共同研究グループ
理化学研究所 環境資源科学研究センター
植物ゲノム発現研究チーム
チームリーダー 関 原明(セキ・モトアキ)
研究員(研究当時) 松井 章浩(マツイ・アキヒロ)
研究員 戸高 大輔(トダカ・ダイスケ)
テクニカルスタッフⅠ 田中 真帆(タナカ・マホ)
研究パートタイマーⅡ 水無 佳代子(ミズナシ・カヨコ)
テクニカルスタッフⅠ 高橋 聡史(タカハシ・サトシ)
研修生(研究当時) 砂押 裕司(スナオシ・ユウジ)
テクニカルスタッフⅠ 石田 順子(イシダ・ジュンコ)
研究員(研究当時) クラーム・バシール(Khurram Bashir)
(現 客員研究員、ラホール経営科学大学 准教授)
環境代謝分析研究チーム
チームリーダー 菊地 淳(キクチ・ジュン)
テクニカルスタッフⅠ 坪井 裕理(ツボイ・ユウリ)
統合メタボロミクス研究グループ
テクニカルスタッフⅠ 小林 誠(コバヤシ・マコト)
筑波大学 生命環境系
教授 草野 都(クサノ・ミヤコ)
横浜市立大学 木原生物学研究所
准教授 川浦 香奈子(カワウラ・カナコ)
研究支援
本研究は、理研-産総研チャレンジ研究「エタノールで世界の食糧問題解決に挑む」、科学技術振興機構(JST)CREST「エピゲノム制御ネットワークの理解に基づく環境ストレス適応力強化および有用バイオマス産生(研究代表者:関原明)」、同A-STEP「エタノール処理による葉物作物への高温障害軽減に関する試験研究(研究代表者:関原明)」、日本学術振興会(JSPS)科学研究費助成事業新学術領域研究(研究領域提案型)「アンチセンスncRNAを介した植物の環境ストレス認識・記憶システムの解析(研究代表者:関原明)」「植物の高温・低温ストレス適応におけるRNA顆粒を介した転写後制御機構の解析(研究代表者:関原明)」による支援を受けて行われました。
原論文情報
- Akihiro Matsui, Daisuke Todaka, Maho Tanaka, Kayoko Mizunashi, Satoshi Takahashi, Yuji Sunaoshi, Yuuri Tsuboi, Junko Ishida, Khurram Bashir, Jun Kikuchi, Miyako Kusano, Makoto Kobayashi, Kanako Kawaura, Motoaki Seki, "Ethanol induces heat tolerance in plants by stimulating unfolded protein response", Plant Molecular Biology, 10.1007/s11103-022-01291-8
発表者
理化学研究所
環境資源科学研究センター 植物ゲノム発現研究チーム
チームリーダー 関 原明(セキ・モトアキ)
研究員(研究当時) 松井 章浩(マツイ・アキヒロ)
研究員 戸高 大輔(トダカ・ダイスケ)
報道担当
理化学研究所 広報室 報道担当
お問い合わせフォーム
